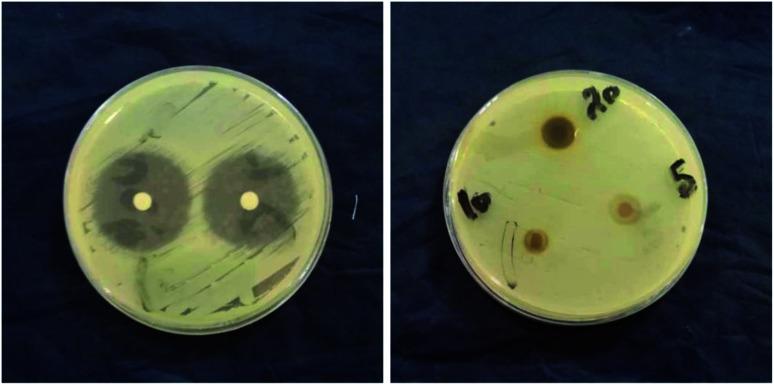
https://cdn.ncbi.nlm.nih.gov/pmc/blobs/5bf7/9419201/fa7f331de637/d1na00509j-f5.jpg

利用绿茶叶提取物绿色合成银纳米颗粒、抗菌活性的表征及评估
Green synthesis of silver nanoparticles using green tea leaf extract, characterization and evaluation of antimicrobial activity.
作者信息
Widatalla Hiba Abbas, Yassin Layla Fathi, Alrasheid Ayat Ahmed, Rahman Ahmed Shimaa Abdel, Widdatallah Marvit Osman, Eltilib Sahar Hussein, Mohamed Alaa Abdulmoneim
机构信息
Department of Pharmacology, Faculty of Pharmacy, University of Medical Sciences and Technology Khartoum Sudan
Department of Pharmaceutical Chemistry, Faculty of Pharmacy, University of Medical Sciences and Technology Khartoum Sudan.
出版信息
Nanoscale Adv. 2022 Jan 18;4(3):911-915. doi: 10.1039/d1na00509j. eCollection 2022 Feb 1.
The use of nanoparticles in medicine, nanomedicine, is very important to diagnose and treat diseases; among the various metallic nanoparticles, silver nanoparticles (AgNPs) are very popular due to their physical, chemical, and biological properties, encompassing a range of activities such as antiviral, antifungal, anti-inflammatory, and anticancer activities. In this study, the synthesis of AgNPs was conducted by the use of a nontoxic, ecofriendly method. Green tea (GT) leaf extract was used as a reducing agent to convert silver ions into free AgNPs. The UV-vis spectrum showed a peak at 410 nm, confirming the presence of AgNPs. A Fourier-transform infrared (FTIR) analysis of the GT extract and GT AgNPs display spectra that is identical to those of polyphenols, polysaccharides, and proteins. All the vibrational peaks in the GT extract spectrum were shifted in the AgNP spectrum, becoming narrower after the encapsulation of nanoparticles. The scanning electron microscopy (SEM) images confirm the presence of AgNPs with different sizes, ranging from 15 to 33 nm. Furthermore, the antibacterial activity of the synthesized AgNPs in three different concentrations (10, 20, and 50 mg ml) showed appreciable inhibition of bacterial growth against and sp. From the above findings, we can recommend the use of AgNPs from GT leaf extracts as an antimicrobial agent to treat chronic infections.
纳米粒子在医学中的应用,即纳米医学,对于疾病的诊断和治疗非常重要;在各种金属纳米粒子中,银纳米粒子(AgNPs)因其物理、化学和生物学特性而非常受欢迎,具有一系列活性,如抗病毒、抗真菌、抗炎和抗癌活性。在本研究中,采用无毒、环保的方法合成了AgNPs。绿茶(GT)叶提取物用作还原剂,将银离子转化为游离的AgNPs。紫外可见光谱在410nm处出现一个峰值,证实了AgNPs的存在。对GT提取物和GT AgNPs进行的傅里叶变换红外(FTIR)分析显示,其光谱与多酚、多糖和蛋白质的光谱相同。GT提取物光谱中的所有振动峰在AgNP光谱中都发生了位移,在纳米粒子包封后变窄。扫描电子显微镜(SEM)图像证实了存在尺寸从15到33nm不等的AgNPs。此外,合成的AgNPs在三种不同浓度(10、20和50mg/ml)下的抗菌活性显示出对 和 菌属细菌生长的明显抑制。根据上述发现,我们可以推荐使用GT叶提取物中的AgNPs作为抗菌剂来治疗慢性感染。